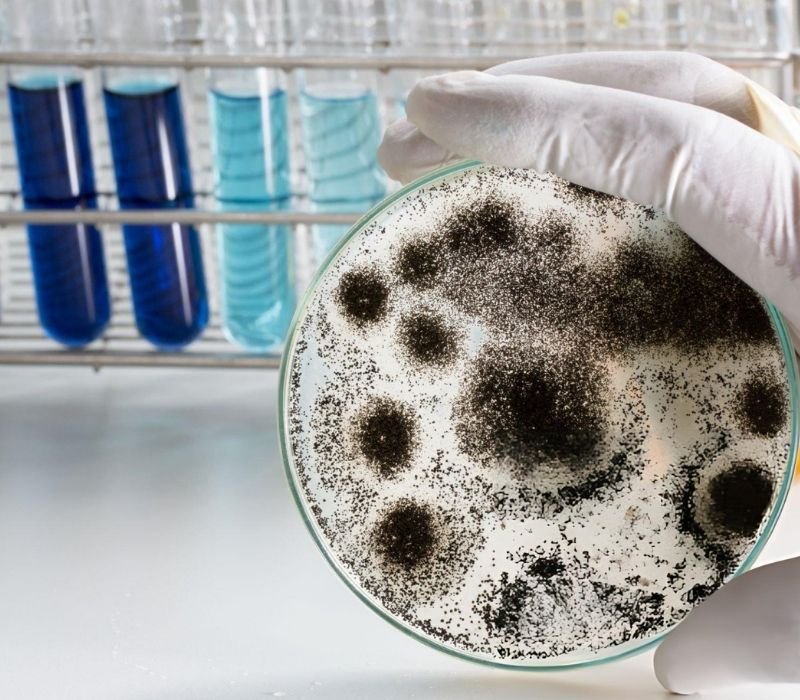
Mold Testing San Diego - Dry Pros

24/7 Emergency Response | Licensed and Insured | IICRC Certified Experts
Mold Removal San Diego
Residential and Commercial Mold Removal Across San Diego County
Mold doesn’t just damage property – it threatens health and safety. At Dry Pros, we deliver expert mold removal San Diego home and business owners trust. With over 30 years of experience, our certified professionals handle everything from black mold removal to crawl space mold removal services in San Diego, protecting your space and restoring indoor air quality. Whether you’re in Downtown San Diego, La Jolla, or Rancho San Diego, our fast, discreet services get the job done right.
Main Causes of Mold in San Diego County
San Diego’s coastal climate, combined with aging infrastructure and frequent leaks, creates ideal conditions for mold growth. Here are the most common causes:
- Plumbing Leaks (pipes, toilets, water heaters)
- Roof Leaks (especially during seasonal rain)
- Poor Ventilation (bathrooms, basements, and crawl spaces)
- Flood Damage (unaddressed moisture from previous flooding)
- HVAC System Issues (condensation, drainage failures)
- High Indoor Humidity Levels
Our San Diego Mold Removal Process
Types of Mold Addressed by Dry Pros
At Dry Pros, we offer deep mold removal services in San Diego that target the most common – and the most dangerous – types of mold found in residential and commercial properties. Whether it’s lurking behind drywall or spreading silently through HVAC systems, our team is trained and equipped to detect and eradicate it at the source.
Black Mold (Stachybotrys chartarum)
We offer certified black mold removal in San Diego using full containment and HEPA filtration systems.
Aspergillus
Our team identifies and removes airborne Aspergillus colonies as part of complete indoor air quality restoration.
Cladosporium
We address surface and subsurface Cladosporium growth with targeted antimicrobial treatments.
Penicillium
Our technicians eliminate Penicillium during both crawl space and drywall remediation projects.
Alternaria
We remove Alternaria growth in moisture-prone areas while providing dehumidification and structural drying to prevent recurrence.
Why Choose Dry Pros for Mold Removal Services in San Diego
Our mold removal experts bring the equipment, experience, and certifications needed for reliable mold removal in San Diego – whether it’s visible black mold or hidden growth behind walls. We follow IICRC S700 standards for professional fire damage restoration in San Diego, ensuring compliance, safety, and long-term protection.
Serving San Diego County’s Commercial and Residential Properties
We proudly serve:
- Downtown San Diego
- Rancho San Diego
- Chula Vista
- Oceanside
- Carlsbad
- Encinitas
- Del Mar
- La Jolla
- Santee
- Poway
- National City
- El Cajon
- Escondido
- Vista
- Solana Beach
- Lemon Grove
- Bonita
- Spring Valley
- Lakeside
- Alpine
- Fallbrook
- Ramona
- Valley Center
- San Marcos
- Julian
Emergency? Call Now.
Dry Pros is the go-to for emergency mold removal services in San Diego. Whether you need urgent attic decontamination or comprehensive crawl space mold removal services in San Diego, we respond 24/7. Don’t wait – the longer mold stays, the more damage it causes.
FAQs – Mold Removal in San Diego
Visible mold, musty odors, or respiratory issues are signs you may need professional help. Our inspection identifies both surface and hidden mold.
Black mold can release mycotoxins that may affect health. We specialize in safe, certified black mold removal San Diego homeowners rely on.
Often, if mold results from a sudden covered event (like a burst pipe), insurance may pay. We handle documentation for your claim.
The process typically takes 1–3 days, depending on the extent and location. Severe cases may take up to a week.
Not if the source of moisture is resolved. We offer full water and mold mitigation to prevent future outbreaks.
Yes. We use EPA-approved methods and secure containment procedures to protect vulnerable individuals during and after removal.
Absolutely. We provide specialized crawl space and attic mold removal services in San Diego with thorough structural checks.
Always choose a company like Dry Pros that is IICRC certified, licensed, and insured for mold remediation.
Contact Dry Pros Today
For certified, compassionate fire damage restoration in San Diego CA, contact Dry Pros now. From fire damage removal to odor elimination and complete rebuilds, we restore your home or business safely and efficiently.
